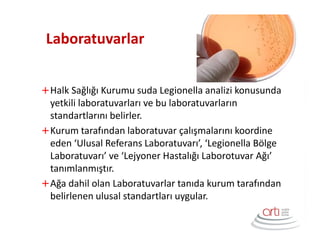
Laboratuvarlar
Halk Sağlığı Kurumu suda Legionella analizi konusunda
yetkili laboratuvarları ve bu laboratuvarların
standartlarını belirler.
Kurum tarafından laboratuvar çalışmalarını koordine
eden ‘Ulusal Referans Laboratuvarı’, ‘Legionella Bölge
Laboratuvarı’ ve ‘Lejyoner Hastalığı Laborotuvar Ağı’
tanımlanmıştır.
Ağa dahil olan Laboratuvarlar tanıda kurum tarafından
belirlenen ulusal standartları uygular.

Lejyoner Hastalığına karşı işletmelerde alınması gereken önlemleri tanımlayan Lejyoner Hastalığı Kontrol, Usul ve Esasları hakkındaki yönetmelik 13 Mayıs 2015’de Resmi Gazete’de yayınlandı. Tüm yataklı sağlık kurumlarını, yataklı tesisleri, günü birlik toplu kullanıma açık eğlence ve dinlence yerlerini, endüstriyel havalandırma ve soğutma sistemlerinin kullanıldığı iş yerlerini ilgilendiren bu yönetmeliği sizler için özetledik..